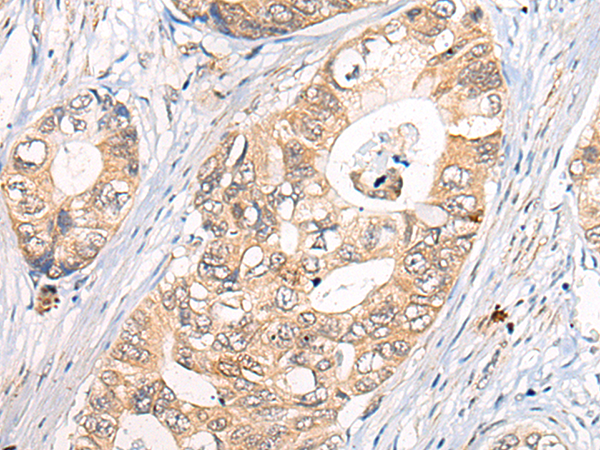

中文名稱:兔抗CLPTM1多克隆抗體
|
Background: |
Clefts of the oral-facial region usually occur in early fetal development and can affect the lip, the soft palate (the soft tissue in the back of the mouth) and the hard palate (the roof of the mouth). Cleft lip (with or without cleft palate) is a genetically complex birth defect that occurs in approximately one in every 750-1,000 live births. This is one of the most common birth defects and is multifactorial, with both genetic and environmental causes. Cleft lip- and palate-associated transmembrane protein 1 (CLPTM1) belongs to a family of cleft lip and palate transmembrane proteins. This family also contains cisplatin resistance-related protein (CRR9), which is involved in CDDP-induced apoptosis. The CLPTM1 protein shows strong homology to two Caenorhabditis elegans genes. |
|
Applications: |
ELISA, WB, IHC |
|
Name of antibody: |
CLPTM1 |
|
Immunogen: |
Fusion protein of human CLPTM1 |
|
Full name: |
CLPTM1, transmembrane protein |
|
SwissProt: |
O96005 |
|
ELISA Recommended dilution: |
5000-10000 |
|
IHC positive control: |
Human gastric cancer |
|
IHC Recommend dilution: |
20-100 |
|
WB Predicted band size: |
76 kDa |
|
WB Positive control: |
Rat brain tissue, Mouse kidney tissue, A172 and Hela cell lysates |
|
WB Recommended dilution: |
200-1000 |

購物車
購物車 幫助
幫助
 021-54845833/15800441009
021-54845833/15800441009
